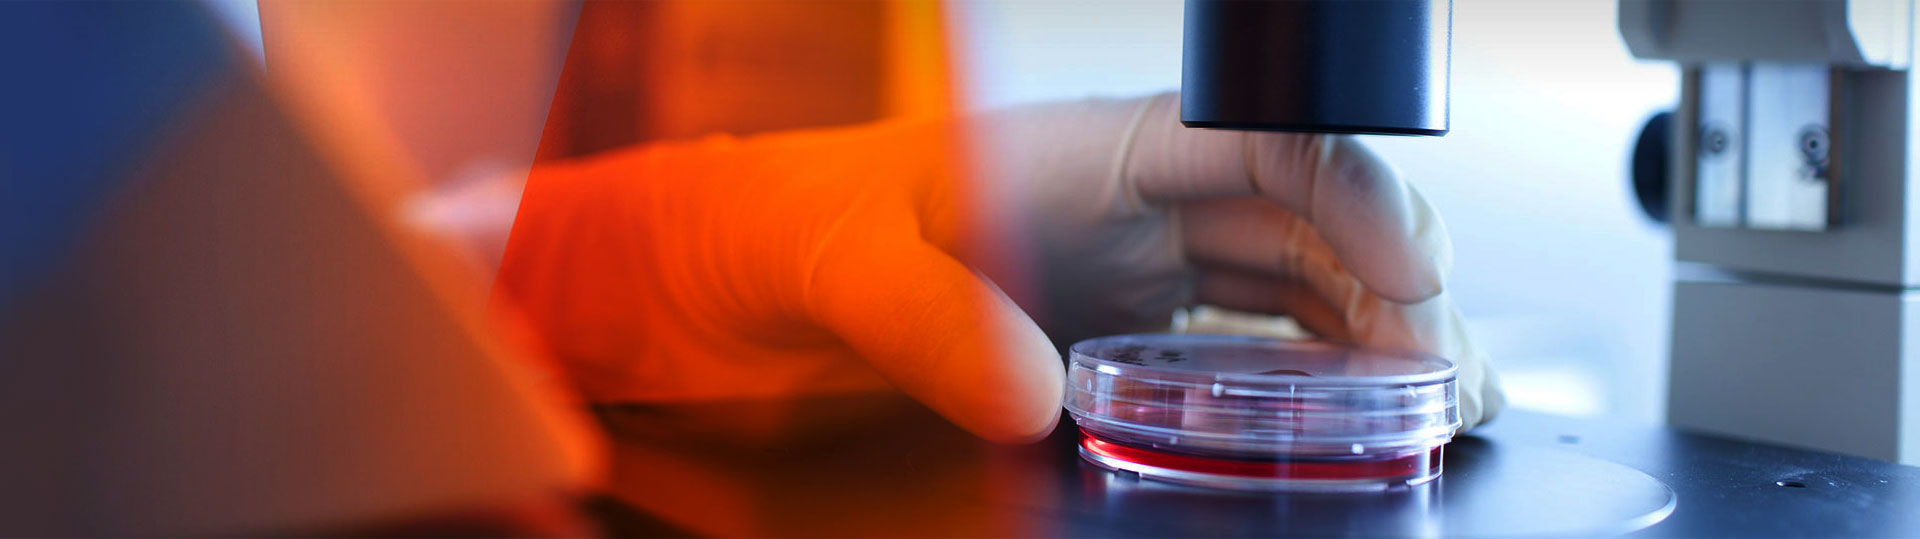

公司生產的高檔苝紅系列產品,具有特殊的可見光反射及透射性能,被廣泛應用在光伏及新能源材料領域,特別是應用在光伏背板及EVA, POE及EPE光伏封裝膠膜上面。
公司生產的高檔苝紅系列產品因其色澤艷麗,產品性能優異,同時屬于環保型有機顏料,被廣泛應用在塑料領域,特別是色母粒及纖維拉絲行業。
公司生產的高檔苝紅系列產品因其色澤艷麗,產品性能優異,指標穩定,被廣泛應用在汽車漆,水性汽車漆及汽車修補漆領域。
公司生產的高檔苝紅系列產品因其色澤艷麗,產品性能優異,指標穩定,被廣泛應用在油墨及涂料印花漿領域。
廣泛應用在醫藥及農藥中間體領域的苝系中間體產品。


















遼寧鴻港化工有限公司成立于2011年6月,是專業研制開發和生產高檔苝紅系產品的精細化工產品生產企業。公司位于遼陽芳烴基地萬和二路6號。占地面積108000平方米,其中建筑面積36,000平方米。
企業現有職工110人,其中大學以上學歷人員35人,擁有中高級專業技術職稱8人。公司設有獨立的研發機構,專門從事試驗研究的開發人員35人。配有專業計算機、氣象色譜、液相色譜,色差儀、分散儀等先進的檢測檢驗設備和設施。在研究開發的項目中,顏料紅149為行業標準的第一起草單位,有10 項苝系產品制備方法被授予國家發明專利,產學研合作的項目2個,10 項產品填補國內空白。